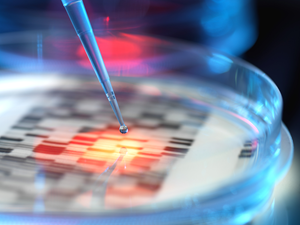

The suit accused the plasma center of failing to obtain informed written consent, failing to provide proper disclosures, and unlawfully collecting and storing thousands of patients’ fingerprints by means of a finger-scanning donor identification system.
Since its passing in 2008, BIPA has made it unlawful in the State of Illinois for any private entity to “collect, capture, … or otherwise obtain a person’s or a customer’s biometric identifier or biometric information” unless various steps are taken, including obtaining informed consent, providing appropriate disclosures, and adhering to certain standards for handling and storing the data.
The plasma center recently reached a deal with the class to settle the suit for $9.9 million, which would provide a significant payout per class member compared to other BIPA settlements to-date. As a part of the settlement, claims and a pending lawsuit against a third-party would be preserved (in it, the plasma center’s software company is accused of storing biometric data without donors’ consent).